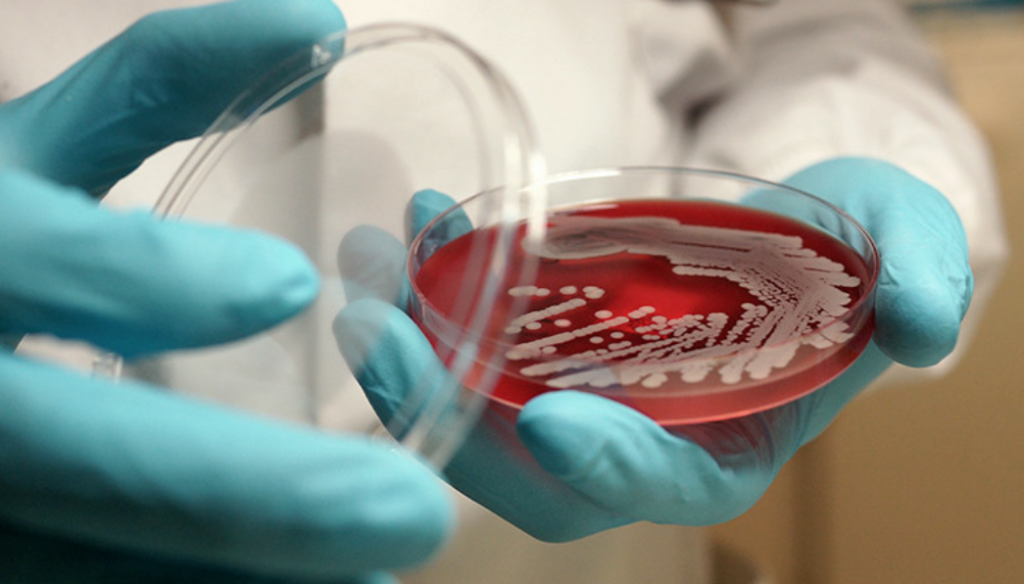
Состояние больных сибирской язвой жителей Топара не изменилось

Оқиғалар лентасы
- Қазақстанда 280-ден астам ирригациялық арналар автоматтандырылуда
- Қазақстанда дропперлер үшін қылмыстық жаза енгізілді
- ІІМ Есірткі мен күшті заттардың айналымын бақылауды күшейтеді
- Қарағанды облысындағы кент тұрғындары жаңа су құбыры іске қосылғаннан кейін проблемаларға шағымданды
- Президент: журналистер ағартушылықтың нұрын қоғамға жеткізеді
- Табысты отбасы дегеніміз не: Қазақстанда қауіпсіздікті бағалау критерийлері жаңартылды
- Қазақстандықтарға жабық схема бойынша жарыққа тарифтер көтеріледі
- Биыл ақпарат саласының 66 қызметкері пәтер кілтін алады-Тоқаев
- "Априори шындыққа жанаспайды". Қазақстандықтардан тапшылықтар мен үзілістер туралы қауесеттерге сенбеу сұралады
- Тоқаев бұқаралық ақпарат құралдары қызметкерлері күнімен құттықтады
- Қазақстанда кейбір өнеркәсіптік жобаларды қолдау шектеледі: заңға қол қойылды
- It сертификаттарын қолдан жасау әрекеттері полицияға жіберіледі
- Қарағайлы байыту фабрикасына бұзушылықтар үшін 3,5 млн айыппұл салынды
- Қазақстанда отбасының әлеуметтік әл ауқатын анықтау әдістемесі нақтыланды
- Қарағандыда Автоледи Тәттімбет көшесінің жабық учаскесіндегі бетон блокқа құлады
- Доватор көшесіндегі үйлерде субұрқақ екінші қабатқа дейін өздігінен соғылады
- Қарағандының орталық саябағында бір топ ит үйрек кемірді
- Барлық ғылыми ұйымдардың қызметкерлері 56 күн демалыс алады: Тоқаев заңға қол қойды
- Қазақстанда ересектерге қандай екпелер қажет - тегін және ақылы вакциналар тізімі
- Теміртауда Қарағанды облысының 90 жылдығына арналған картиналар көрмесі ашылады
- Қазақстанда балалар лагерлеріне лицензия алу жеңілдетілді
- Ермағанбет Бөлекпаев Қарағанды облысы тұрғындарының жеке қабылдауын өткізді
- Цифрландыру, дербес деректерді қорғау және жол қозғалысы туралы маңызды заңға Тоқаев қол қойды
- Қарағанды облыстық соты 90 жылдық мерейтойын атап өтуде
- 25 маусым: күндер, оқиғалар және қызықты фактілер
- Нөсер, найзағай және қатты жел: Қарағанды мен облыста 25 маусымға арналған ауа райы болжамы
- Теміртауда екі жасар бала екінші қабаттың терезесінен құлады
- Қазақстан шілде айынан бастап цифрлық әскерге шақыруға көшеді
- Қазақстандықтарға қымбат жылжымайтын мүлікке салық төлемегені үшін не қауіп төндіреді
- "Сөйлейтін" дрондар Қазақстанның жағажайларында ұшуды бастады
- Қаржы министрлігі Мемлекеттік қарыз шығындарының күрт өсуіне дайындалуда
- Қазақстан фермерлеріне жылдық 5-6% жеңілдікпен жаңа несиелер қолжетімді болды
- "Олар қалтасына тиген кезде ғана біледі": ІІМ басшысы"айыппұл" туралы сынға жауап берді
- Бес тілді біле отырып, қарағандылық полиция қызметкері адамдарға шетелде демалыста да көмектеседі
- Қазақстанда аналар қандай төлемдер алады: жәрдемақылар мен жеңілдіктердің толық тізімі
- Kaspi.kz Түркияда Rabobank A. SH сатып алу үшін реттеушінің мақұлдауын алды.
- Қазақстандық мерзімді басшылар өнімдерді тікелей әскери бөлімге тапсырыс бере алады
- Балаларға арналған SIM-карталар Қазақстанда жаңа ережелер бойынша ресімделетін болады
- Орталық саябақта сусындары бар Автомат Қарағандының шағымынан кейін тексеріледі
- Дүкендер көгершіндермен екі мыңдық вексельдерді қабылдауды тоқтатты: егер олар қолында қалса не істеу керек
- Балаларға ерте көмек көрсету Қазақстанның төрт өңіріндегі ауылдық ауруханаларда қолжетімді болады
- Қарағанды облысы Ішкі сауда көлемі бойынша Қазақстанның топ-5 өңіріне кірді
- Қазақстан Парламенті палаталарының бірлескен отырысының күні белгіленді
- Қарсы жолаққа шығу Қарағанды облысындағы тас жолда апатқа әкелді
- Александр Марочкин"Шахтерге" көшуге келісті
- Қазақстанда ЭЦҚ бойынша авторландыру жүйесі күрделене түсті
- Чкаловтағы жанжалды құрылыс
- Қарағанды облысында ормандарға баруға тыйым салынды
- "Сатқындармен әңгіме қысқа": Саденов антты бұзған полиция қызметкерлері туралы айтты
- Қарқаралы маңында дала өрттерімен күрес жалғасуда
- Қазақстанда цифрлық зияткерлік электр желілерінің жобасы пысықталуда
- "Гүлдер аз" : қарағандылықтар қаладағы гүлзарлардың жай-күйіне шағымданды
- Тоқаев Еуропаны Қазақстанда АИ, агросектор және криптоиндустрияны дамытуға шақырды
- Қазгидромет еліміздің бірқатар облыстарында құрғақшылық қаупі туралы ескертті
- Қарағанды облысының ауылдарында жаңа шамдар орнатылуда
- Қызмет, естелік және Құрмет: Қарағанды облысында полиция қызметкерлері марапатталды
- "Таза Қазақстан": Саран жастары су қоймасының жағалау сызығын тазартты
- 24 маусым: судьялар күні, дипломатиядағы әйелдер және тарихтың маңызды беттері
- Жаңбыр мен найзағай салқын болады: Қарағанды мен облыста 24 маусымға арналған ауа райы болжамы
- Қанша қазақстандық құмар ойындарын ойнауға тыйым салды
- Денсаулық сақтау министрлігі мемлекет реттейтін дәрі-дәрмектер тізімін жаңартады
- Қазақстанның үздік отбасы атағы үшін мыңдаған қатысушылар таласады
- Қазақстанда қандай су қоймалары жаңа энергия көздеріне айналады
- "Сұрақ ашық". Зейнетақыны алу үшін жеткіліктілік шегі әлі де өзгеріске ұшырауы мүмкін
- Денсаулық сақтау министрлігі қазақстандықтарды қауіпті жазғы ауру туралы ескертті
- Электромобильдерді зарядтау, дүкендер мен демалыс аймақтары: Қазақстан трассаларында 250 жол бойындағы станция пайда болады
- ҚТЖ Қазақстанның темір жолдарында бірыңғай цифрлық желіні құрады
- Қарағандыда жөндеу жұмыстарына байланысты Мұстафин көшесінің учаскесі уақытша жабылады
- Қазақстандағы көппәтерлі үйлерді жөндеуге 20 млрд теңгеден астам қаражат бөлуді жоспарлап отыр
- Қарағандының орталық саябағында ғашықтардың мүсіні бөлшектелуде
- "Жан сақтаушылар" не туралы үнсіз: қарағандылықтарды Вера Капинус көрмесіне шақырады
- Энергия блоктарынан жылу желілеріне дейін: Қазақстан жылыту маусымына қалай дайындалуда
- Сүт және қосымша демалыс: зиян үшін жеңілдіктер алушылардың тізімдері Қазақстанда қайта қаралады
- Балқаш мыс балқыту зауыты экологиялық бұзушылықтар үшін миллиондаған ақша төлейді
- Заңнама талаптарын сақтау бойынша профилактикалық жұмыс Қарағанды облысында жалғасуда
- Күзетте тәулігіне 24 сағат: Қазақстанда полиция күні атап өтіледі
- Қазақстан қызанақты әкелуге уақытша тыйым салды
- Тоқаев ара шаруашылығы туралы Заңға қол қойды: омарта иелері үшін не өзгереді
- Қарағанды облысында Халықаралық Олимпиада күні ерекше атап өтілді
- Өмірінің соңына дейінгі төлемдер: Қазақстандағы зейнетақы аннуитетін сатып алушылар қандай сомаға сене алады
- Қарт қазақстандықтар туыстарына көмектесемін деп ойлап, соңғы ақшаларын бейтаныс адамға берді
- Қарағанды-Шахтинск тас жолында "ақылды" жарықтандыру орнатылды
- ІІМ бетті тануға кедергі келтіретін киім кигені үшін жауапкершілік туралы еске салды
- Қарқаралы ауданында екі ірі дала өрті сөндірілуде
- Дар басшылары Қазақстанның бірқатар өңірлерінде тағайындалды
- Заң және тәртіп: есірткіге қарсы ауқымды акция Теміртауда өтті
- Бірінші талапкер бейнежазбаларды тексергеннен кейін негізгі ҰБТ дағы ұпайларынан айырылды
- Тоқаев заңсыз аң аулағаны үшін жауапкершілікті қатаңдату туралы Заңға қол қойды
- Қазақстандықтар табалдырықтарды көтергеннен кейін өз зейнетақыларын алудың жолын тапты
- "Таза Қазақстан" іс-әрекетте: фестивальден кейін Балқашта ауқымды тазалау жүргізілді
- Әлеуметтік желілердегі арандатулар қатаң түрде тоқтатылады-Бас прокуратура
- Ұялы байланыстың жаңа ережелері: 28 маусымнан бастап не өзгереді
- 23 маусым: Қазақстан полициясы күні, Олимпиада күні және әлемдік тарих беттері
- Ыстық ауа райы сақталады: Қарағанды мен облыс үшін 23 маусымға болжам
- Қазақстандық колледждерге құжаттарды қабылдау 25 маусымда басталады: қанша грант бөлінді
- Қазақстан Еуроодақтан гранттық қаржыландыру көлемін ұлғайтты
- Қазақстанда жаңа Салық кодексінің нормаларының бірін алып тастау туралы шешім қабылданды
- Бизнес шағымдарынан кейін сауда министрлігі "е-КТРМ" жүйесі бойынша жұмыс тобын құрады
- Телефондардағы маңызды қосымшаларға тәулік бойы тегін қолжетімділік қазақстандықтарға беріледі
- Қазақстанда туу көрсеткіші 20 жыл ішінде ең төменгі деңгейге дейін төмендеді
- Курьер-аналарға төленетін әлеуметтік төлемдерді алып тастау жоспарда жоқ-ҚР Еңбек министрлігі
- Депозиттер Қазақстандағы инфляцияны төмендетуге қалай көмектеседі
- Жинақтарды алу шектерінен кейін Қазақстанда зейнетақы аннуитетінің құны арта ма
- Келешегі бар Туризм: Балқашта алғашқы индустриялық туристік аймақ құрылуда
- Мектептерге арналған жаңа ережелер: оқушыларды, ата-аналарды және мұғалімдерді қандай өзгерістер күтеді
- БЖЗҚ зейнетақы активтерінің кірістілігі өсе бастады, бірақ әлі инфляцияны қамтымайды
- Қазақстан импортты 39 азық түлік позициясы бойынша шектейді
- Әкімнің қала тұрғындарымен кездесуі Теміртауда өтеді
- Ежелгі дәуірдің құпиялары: Қарағанды облысында бір қорғаннан қола дәуірі мен ерте темір дәуірінің жерленген жерлері табылды
- Қазақстандықтар елорда күніне қанша күн демалады
- Balkhash Tour Fest-2026: рекордтар Орнатылатын фестиваль
- Қарағандыда жүргізуші екі күшікті көшіріп алды
- Қарағандыда қазақстандық Полиция күні қарсаңында жарқын мереке өтті
- Қазақстандықтар маңызды мобильді қосымшаларға тәулік бойы тегін қол жеткізе алады
- Үйдің "Шахтері" Бірінші лига матчында "Жайықты" жеңді
- Автолизинг Қазақстанға осы жазда оралуы мүмкін
- Балқаш жағалауында жаңа құтқару станциясы ашылды
- Қазақстанда аэротакси жобасы үшін өндірушілер таңдалды
- Күніне бес мыңға дейін автомобиль: қарағандылықтар Балқашқа жаппай демалуға барады
- Білім саласындағы жаңа түзетулер: олар педагогтардың құқықтарын қорғай ала ма?
- Қазақстанда ядролық сынақтардан зардап шеккендердің бірыңғай тіркелімін құру ұсынылды
- 1 шілдеден бастап Қазақстан жаңа Конституция бойынша өмір сүре бастайды: азаматтар үшін не өзгереді
- Баян Нұртаева Қарағанды облысының Балалардың құқықтарын қорғау басқармасының басшысы болып тағайындалды
- 22 маусым: еске алу күні, жазғы дәстүрлер және әлемдік тарих оқиғалары
Сауалнама
- Әрине. Ол қазірдің өзінде қалтасын айтарлықтай ұрады;(454)
- Мен айырмашылықты сезбедім/а(1401)
Состояние больных сибирской язвой жителей Топара не изменилось
фото: pokayadoma.ru
фото: pokayadoma.ru Состояние больных сибирской язвой жителей Топара осталось неизменным, - со ссылкой на управление здравоохранения Карагандинской области сообщает корреспондент ekaraganda.kz.
В пятницу, 27 октября, 62-летний житель Топара попал в реанимационное отделение Областной клинической больницы города Караганды. Как ранее сообщала руководитель управления здравоохранения области Бибигуль Тулегенова у него произошло усиление кожно-воспалительного синдрома и нарастание объема отека, поэтому он был переведен в реанимацию. У него кожная форма сибирской язвы, тяжелое течение.
По информации врачей, за выходные состояние этого пациента осталось без изменений. Он получает лечение в полном объеме.
Состояние второго 41-летнего больного оценивается, как средней степени тяжести. Он находится в нейробоксированном отделении инфекционного центра. Также получает лечение.
Еще один пациент, у которого сибирская язва не подтвердилась, по-прежнему находится под профилактическим присмотром врачей.
Напомним, в поселке Топар был зарегистрирован локальный случай сибирской язвы. Заболели члены одной семьи. Один из больных сибирской язвой утром, 27 октября, скончался.
Поселок Топар переживает 15-дневный карантин.
Поделитесь мнением об этой новости в нашем Instagram по ссылке.











 vk
vk facebook
facebook twitter
twitter ok
ok mail.ru
mail.ru instagram
instagram youtube
youtube
 Хабарландырулар
Хабарландырулар
 Ауа райы
Ауа райы Медиа
Медиа Анықтамалық
Анықтамалық












































































































